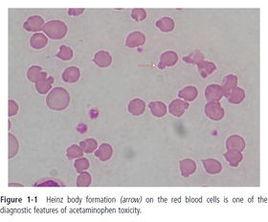
變性珠蛋白小體

蛋白簡介
由於紅細胞內血紅蛋白的結構異常導致珠蛋白發生變性形成。含有這種小體的紅細胞大多在單核-巨噬細胞系統內被吞噬和破壞,造成血管外溶血。
參考值
正常紅細胞不含有變性珠蛋白小體。含有5個以上變性珠蛋白小體的紅細胞,正常人占0~28%,平均值為11.9%。有的作者提出32.5%為正常與異常分分界線。
臨床意義
G-6-PD缺乏症不穩定血紅蛋白溶血性貧血的患者平均達67.8%(45%~92%)。
由於含變性珠蛋白小體的紅細胞通過脾臟時,多被巨噬細胞吞噬,所以未經脾切除的患者往往直接染色檢查不能查到變性珠蛋白小體,在此種情況下應採用本法對診斷具有一定價值。變性珠蛋白小體系變性的血紅蛋白顆粒,一般附著於紅細胞膜上。當紅細胞缺乏G-6-PD時TPNH生成減少,致紅細胞內GSH減少,紅細胞變得不穩定,易受氧化藥物的作用而使血紅蛋白變性,形成珠蛋白小體。不穩定血紅蛋白由於血紅蛋白分子中某些胺基酸發生替代或缺失,使血紅蛋白分子不穩定,易被氧化而形成變性珠蛋白小體,因此檢出變性珠蛋白小體對G-6-PD缺乏症及不穩定血紅蛋白溶血性貧血具有診斷價值。此外在HbH患者也可檢出變性珠蛋白小體。G6PD活性正常時,紅細胞通過磷酸戊糖旁路形成NADPH使MHb還原成亞鐵血紅蛋白,因而含5個或5個以上變性珠蛋白小體的紅細胞減少,而G6PD活性減低時,NADPH減少,MHb增多,導致含5個或5個以上變性珠蛋白小體的紅細胞增多,不穩定血紅蛋白由於血紅蛋白分子結構發生改變,穩定性減低易被氧化,含5個或5個以上變性珠蛋白小體的紅細胞可增多,伯氨喹啉型溶血性貧血,含變性珠蛋白小體的紅細胞也可增多。
生成試驗
又稱“變性珠蛋白小體檢驗"、“乙醯苯肼生成試驗"。不穩定血紅蛋白(Hb)、血紅蛋白H(Hb-H)等異常Hb在紅細胞內可發生沉澱,形成變性珠蛋白小體。經結晶紫染色後可在光鏡下看到。由於脾臟對含有珠蛋白小體紅細胞的清除作用,血標本珠蛋白陽性率極低。將血液與乙醯苯肼混合,置37℃孵育2h(加速Hb氧化和糖代謝,可提高陽性率)後製片,用結晶紫染色後鏡檢計數。正常值:普通法陰性;生成法(加乙醯苯肼後)含5個以上珠蛋白小體的紅細胞<30%。Hb-H、不穩定Hb、G-6-PD缺陷、硝基苯、苯胺中毒等 可為陽性,生成法>40%。
注意事項
在試驗過程中嚴格控制加入乙醯苯肼的量,製片後立即計數,久置會降低陽性率且要作正常對照,同時注意含變性珠蛋白小體的紅細胞與網織紅細胞的鑑別。